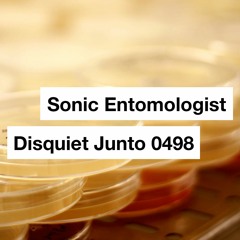
Unstable Organism (disquiet0498)

metrotechno
mirth
50
3:30
Dec 16, 2016
2
techno experiment, straight out of the modular.
- Intellijel Metropolis provides clock and drives Intellijel Rubicon
- main synth audio: Rubicon sub -> A-103 VCF6 -> Polaris -> uVCA2
- main synth envelope: Mutable Instr…

![[disquiet0498] Gravid](https://i1.sndcdn.com/artworks-W5LYmP5i9VUPC9fa-yAPX8w-t240x240.jpg)
